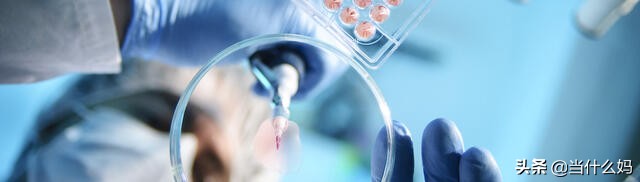
有机致臻有机奶粉怎么样,国产奶粉真的那么好吗

本期登场:有机奶粉
依然在开头先强调一下,测评的大部分奶粉,我自己没有买过、也没有给小臭吃过。我的测评更多地是从品牌、营养配方、奶源、价格这些方面去分析,并且会在里面穿*我插**对于辅食和喂养的一些看法。介意的右上角点叉哦,谢谢!
还是那句话:没有最完美的奶粉,只能说性价比比较高、或者更适合你家宝宝的奶粉。希望我的测评,能够给不知道如何给宝宝挑选奶粉的你,一点小启发~
关注我,看往期更多测评:
- 第1期:这款国产奶粉添加了11项营养配方,但对于1岁以上宝宝,没有必要
- 第2期:钢琴家郎朗代言,这款高端奶粉,曾被调侃披着“洋”皮
- 第3期:诺优能和牛栏到底什么关系?我缕清楚了,还做了国行的5点测评
- 第4期:章子怡代言的飞鹤,有各种飞帆系列,来看看我对这款飞帆的测评
- 第5期:李娜代言的国行奶粉,4个段数的价格都差不多,只因添加了这个

- 奶粉小测评-第6期:爱尼可有机,国产版
虽然第一次测评有机奶粉,但其实之前已经专门写过一次有机了,《什么是有机奶粉?其实只要搞清楚,4个优点和1个缺点就好了》,本文的测评也基本跟着这篇来的。
品牌
孤陋寡闻,不是有人来咨询的话,又是一个我没听过的牌子……
爱尼可有机是北安宜品的一个系列。北安宜品(Yeeper),全称北安宜品努卡乳业有限公司,前身是北安市乳品厂,是有着65年历史、集研发+生产+销售一条龙的乳制品企业。生产基地在黑龙江小兴安岭,也算国内的黄金奶牛饲养带了,并且坐拥国内不多的有机牧场(好腻害的样子……)
“宜品”的宣传语是:宜人宜己,品质中国;标语“有机生态,敬天爱人”等还蛮拉好感。其官网的宣传是不仅有着60多年的专业奶粉生产经验,并且“60年安全生产零事故”。不过参考年度收入、利润等指标,宜品在婴幼儿配方奶粉行业还算不上大品牌,只能说还有成长空间吧。

除了爱尼可有机,北安宜品旗下还有蓓康僖羊奶粉、金装益生菌、益膳、益臻等系列。
奶源
如上,爱尼可有机的奶源在黑龙江,作为有机奶粉,在奶源方面本身就具备着优势:奶牛不打激素,牧草等原料在种植时不能播撒农药、化肥;牧场的水源、空气、土壤,都要符合有机的无污染的标准要求。包括有机奶粉的认证也比较严苛,要在满足以上条件的基础上,再由多个权威部门检测、检验,所以在安全方面是比普通奶粉更有保证的。

不过可惜的是,爱尼可有机的3段奶粉里面,只有1段是用有机鲜奶生产,2段和3段都掺入了还原奶;并且3段的价格都在380元左右~所以和上一期的卓萃一样,爱尼可也并没有在care鲜奶和还原奶生产的区别,重点还是卖“有机”这个概念。
还原奶的生产工序是:先把鲜奶制成粉,再运到其他地方,兑水,再制成奶粉,所以新鲜度和营养保留度肯定是没有用鲜奶生产的奶粉好的,并且也相对容易受到二次污染。
营养
有机奶粉的优点,除了奶源、牧场和认证外,还有一点是生产过程:有机奶粉在生产的全过程中,要控制化学手段的使用,限制非有机原料的添加,不允许添加过多的人工合成营养素——有机原料的添加至少要达到95%,这也意味着人工合成的营养配方会比较少。
所以成也萧何,败也萧何,有机奶粉的缺点就在于营养配方普遍较少。
从基础营养配方来看,爱尼可有机的1段添加了DHA(促进脑部发育)、胆碱(促进脑部发育)、益生元(调理肠胃、促进吸收)、ARA(促进神经系统发育)四项,没有添加牛磺酸(促进脑部、神经、视觉发育,促进钙、脂吸收)和核苷酸(促进新陈代谢),2段和3段又减了ARA。
从特色营养配方来看,3个段数都没有添加。
这和我们前几期动辄6种常规营养配方+n种特色营养配方的国产奶粉相比,确实不占优势。但是爱尼可这个营养添加在有机奶粉里面,其实已经不算差的了。国内比较早做有机奶粉的雅培菁挚,其实也就这个配置……
原料
原料方面也很省心,没有什么需要特别注意的~
价格

(来源:某东)
如上所说,爱尼可3个段数的差价就几块钱,基本在380元左右。
19元/100g,388元/800g(1段,0-6月龄,婴儿配方奶粉)
379元/800g(2段,6-12月龄,较大婴儿配方奶粉)
379元/800g(3段,12-36月龄,幼儿配方奶粉)
查价格的时候刚好在秒杀,3个段数都是318元/800g,100g试用装是15.9元~不知道是不是常规的价格。
总结
关于有机奶粉,其实测评下来应该都差不多,看家长的个人选择和偏好吧:是想更安全,还是更营养?

你给宝宝喝过爱尼可有机奶粉吗?欢迎分享!
感谢阅读!我是多平台优质育儿领域创作者@当什么妈 ,同时也是公务员妈妈、文学硕士、健康管理师。关注孩子和自我的成长,更新不定,选题随心,盼你同行。